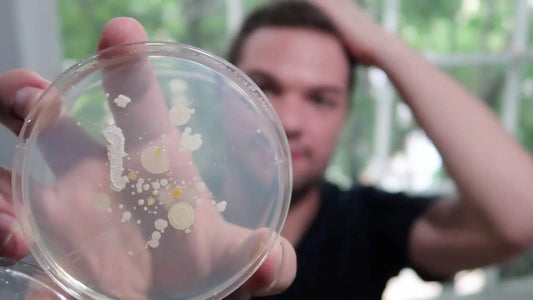
Testing My Skincare Products for BACTERIA! (Gross) - Nick DiRamio

Blog de desglose de clips
Resúmenes escritos de cada episodio de Clip Breakdown,
Desglose de clips

Revisión de Hawthorne_ Gel de baño, jabón y des...
https://youtu.be/FoZiW0DIS1M ¡Es hora de otra entrega de Probar productos de Instagram! Hoy compré algunos nuevos productos de baño para hombres diseñados especialmente para mí por Hawthorne.co, que utiliza un cuestionario...
Revisión de Hawthorne_ Gel de baño, jabón y des...
https://youtu.be/FoZiW0DIS1M ¡Es hora de otra entrega de Probar productos de Instagram! Hoy compré algunos nuevos productos de baño para hombres diseñados especialmente para mí por Hawthorne.co, que utiliza un cuestionario...
¡Prueba mis productos para el cuidado de la pie...
Es hora de admitirlo: las bacterias me asustan cuando se trata de mis rutinas diarias de cuidado de la piel por la mañana y por la noche. Lavarme las manos...
¡Prueba mis productos para el cuidado de la pie...
Es hora de admitirlo: las bacterias me asustan cuando se trata de mis rutinas diarias de cuidado de la piel por la mañana y por la noche. Lavarme las manos...

Prueba de gafas de luz azul: ¿son una estafa?
Livhò Comprar en Amazon https://youtu.be/Asoz9i4ZMjY Probablemente ya hayas escuchado que la luz azul de las pantallas de nuestros teléfonos y computadoras puede ser perjudicial para la vista y causar problemas...
Prueba de gafas de luz azul: ¿son una estafa?
Livhò Comprar en Amazon https://youtu.be/Asoz9i4ZMjY Probablemente ya hayas escuchado que la luz azul de las pantallas de nuestros teléfonos y computadoras puede ser perjudicial para la vista y causar problemas...

¿Qué hay REALMENTE en Touchland Power Mist?
https://youtu.be/LLzF102w46I ¡Hace unos meses compré CADA AROMA de Touchland para desempaquetarlo y experimentarlo con todos ustedes! Más tarde, Touchland se acercó para colaborar en este video, donde quería llevarte al...
¿Qué hay REALMENTE en Touchland Power Mist?
https://youtu.be/LLzF102w46I ¡Hace unos meses compré CADA AROMA de Touchland para desempaquetarlo y experimentarlo con todos ustedes! Más tarde, Touchland se acercó para colaborar en este video, donde quería llevarte al...

Harry y Meghan se convierten en miembros reales...
https://youtu.be/6j0JkqqmG-I En Estados Unidos estamos obsesionados con la familia real británica. Por eso nos encanta la historia de Meghan Markle casándose con el príncipe Harry. Un año después de la...
Harry y Meghan se convierten en miembros reales...
https://youtu.be/6j0JkqqmG-I En Estados Unidos estamos obsesionados con la familia real británica. Por eso nos encanta la historia de Meghan Markle casándose con el príncipe Harry. Un año después de la...

Revisión de la piel de Kylie y primeras impresi...
https://youtu.be/MOV9CGpPDyo Salté tan pronto como salió a la venta la línea de cuidado de la piel Kylie porque sabía que se agotaría al instante. ¡Yo tenía razón! Afortunadamente, conseguí algunos...
Revisión de la piel de Kylie y primeras impresi...
https://youtu.be/MOV9CGpPDyo Salté tan pronto como salió a la venta la línea de cuidado de la piel Kylie porque sabía que se agotaría al instante. ¡Yo tenía razón! Afortunadamente, conseguí algunos...